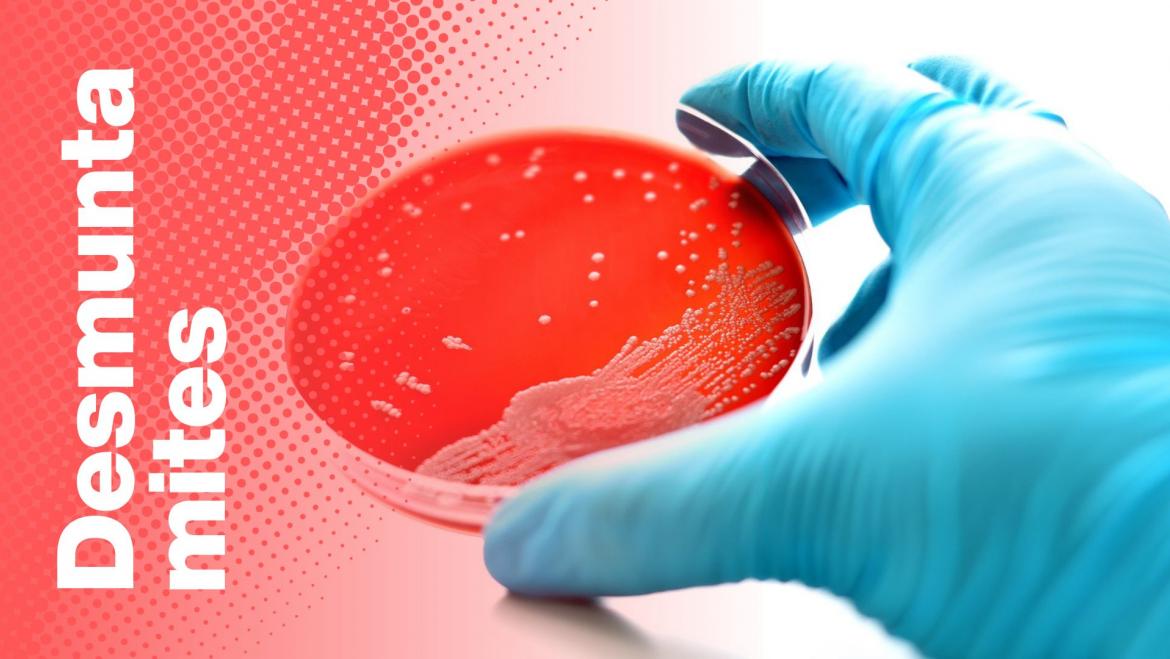
desmuntamites
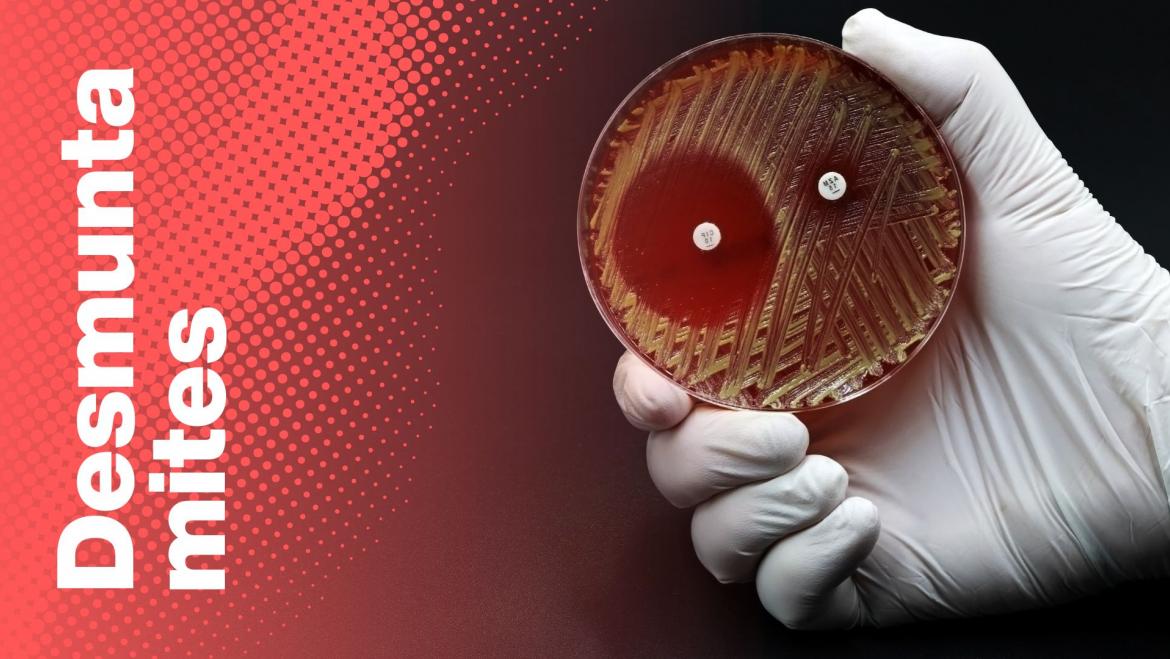
desmuntamites Septicèmia

L'acceptació d'aquestes condicions, suposa que doneu el consentiment al tractament de les vostres dades personals per a la prestació dels serveis que sol·liciteu a través d'aquest portal i, si escau, per fer les gestions necessàries amb les administracions o entitats públiques que intervinguin en la tramitació, i la seva posterior incorporació en l'esmentat fitxer automatitzat. Podeu exercitar els drets d’accés, rectificació, cancel·lació i oposició en relació amb la subscripció al butlletí Fes Salut adreçant-vos per escrit a comunicacio.bellvitge@bellvitgehospital.cat, indicant clarament a l’assumpte "Exercici de dret LOPD".
Responsable: Hospital Universitari de Bellvitge.
Finalitat: Gestionar el contacte de l'usuari
Legitimació: Acceptació expresa de la política de privacitat.
Drets: Accés, rectificació, supresió i portabilitat de les dades, limitació i oposició al seu tractament.
Procedència: El propi interessat.